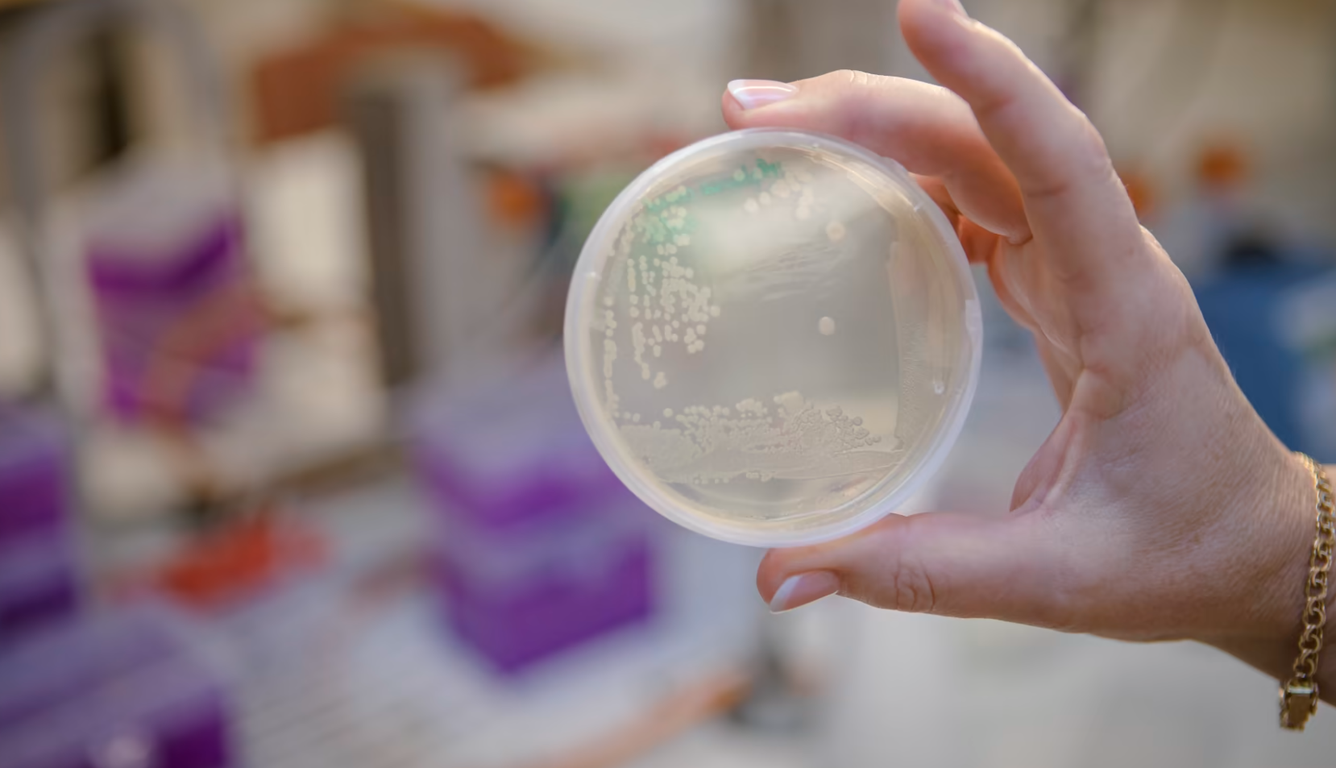
🧫 Ny typ av antibiotika dödar multiresistenta bakterier

💖 Visualisering ska ge bättre och säkrare hjärtoperationer
En modell ska i framtiden kunna simulera hjärtoperationer och visa vilken procedur som är bäst för varje enskild patient.
🧒 Barnfattigdomen i USA har minskat med 59 procent
Fler hushåll med två närvarande föräldrar och bättre möjlighet för ensamstående mödrar att kunna arbeta är några av anledningarna till minskad barnfattigdom.
🔋 Nytt batteri kan ge snabbare snabbladdning för elbilar
Bättre reglering av batteriets temperatur under laddning ska ge snabbladdning även på mindre batterier och garantera att en laddning inte tar mer än tio minuter.
🏠 Kinas nya vindkraftpark ska lysa upp 13 miljoner hem
En vindkraftspark till havs med tusentals vindkraftverk kommer att bli Kinas största vindkraftspark.
🧬 Nytt cancertest kan se farliga cellförändringar långt i förväg
Ett nytt screeningtest för livmoderhalscancer kan upptäcka höggradiga cellförändringar innan de är möjliga att se med dagens metoder.
🚗 Biltillverkarna dubblar investeringarna i elbilar
Världens biltillverkare kommer att satsa över en biljon dollar fram till 2030 då hälften av alla bilar som byggs kommer att vara eldrivna.
🧫 Ny typ av antibiotika dödar multiresistenta bakterier
En ny klass av antibiotika kan stoppa en rad bakterier som är resistenta mot antibiotika idag.
Vindkraft på varje hustak med miniturbiner
Små vindturbiner som inte behöver några stora snurrande blad kan ge oss vindkraft på taken.
💰 415 miljoner färre fattiga människor i Indien på 15 år
En massiv minskning av antalet fattiga i Indien under de senaste 15 åren visar att det går att eliminera fattigdom.